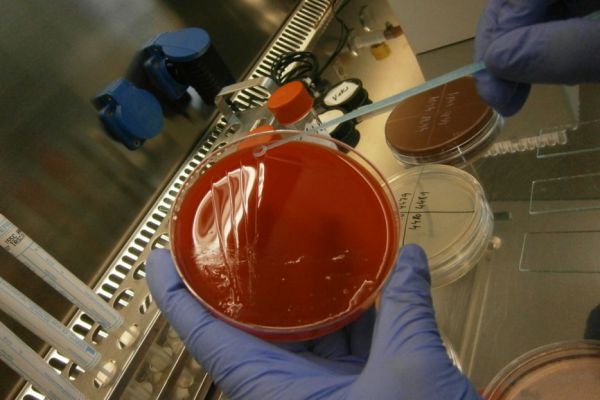

- Oddělení zpracovává mikrobiologické vzorky z nemocnice a spádových oblastí okresu Břeclav. Provádíme vyšetření bakteriologická i serologická.
- Provádíme vyšetření základní infekčních markerů pro transfuzní oddělení, dále základní serologická vyšetření a rovněž kultivační vyšetření a stanovení citlivosti na atb.
- Pro nemocniční pacienty, ale i pro praktické lékaře z okolí nabízíme tato serologická vyšetření: ASLO, ANA, serologie borelií – IgM i IgG pro B.afzelii, B.garini, B. burgdorferi, dále WB pro výše uvedené borelie, EBV, CMV, vyšetření protilátek IgA, IgM, IgG chlamydií a mykoplazmat, vyšetření IgM a IgG toxoplazmozy, IgM a IgG anaplazmy, dále vyšetření protilátek na brucelu, listerii a tularemii, atanovení protilátek anti HBsAg, HAV, HCV, HIV, SYF.
- Kultivační vyšetření včetně antibiogramu ze stěrů z krku, nosu, gynekologického a urologického materiálu, moče, chirurgické rány, vyšetření sputa či BALu, vyšetření žaludeční tkáně na přítomnost helikobaktera, vyšetření stolice včetně parazitů, LPX, adeno, rotavirů, norovirů, vyšetření na přítomnost Cl. difficile včetně toxinů, pro pacienty nemocnice vyšetření likvoru a hemokultury.
- Dále provádíme základní mykologické vyšetření výše uvedených materiálů.
- Certifikát Státního zdravotního ústavu v Praze, zkoušení způsobilosti v oblasti lékařské mikrobiologie.
- Osvědčení o účasti SEKK, Poskytovatel zkoušení způsobilosti č.7004 akreditovaný ČIA dle ČSN EN ISO/IEC 17043
- Osvědčení o akreditaci č.349/2025 pro oddělení laboratorní mikrobiologie
- Seznam činností laboratoře v rámci flexibilního rozsahu akreditace
Oddělení laboratorní mikrobiologie ☏
Kde nás najdete: Pavilon C – 1. patro
Provozní doba: 7.00–15.30 hod.
E-mail: mikrobiologie@nembv.cz
MUDr. Kateřina Wagnerová

Vedoucí laboratoře
Mgr. Olga Tesárková

Vedoucí laborantka
Příjem vzorků mikrobiologie
Laboratoř klinická
Serologie
Soubory ke stažení
Osvědčení o akreditaci OLM
[PDF, 4,9 MB]
Seznam činností laboratoře v rámci FRA
[PDF, 362,15 KB]